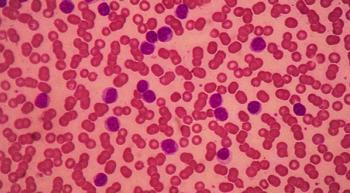

Patients with chronic lymphocytic leukemia are at risk for an increased number and severity of infections due to both their disease and its treatment, an expert explained during the CURE® Educated Patient® CLL Summit.

Patients with chronic lymphocytic leukemia are at risk for an increased number and severity of infections due to both their disease and its treatment, an expert explained during the CURE® Educated Patient® CLL Summit.

An expert provided an overview of the promising therapies that are being investigated for the treatment of patients with chronic lymphocytic leukemia.

Recent years have brought more targeted agents to the frontline treatment for patients with chronic lymphocytic leukemia.
Autoimmune diseases in patients with CLL are separate from CLL, which calls for different treatments.